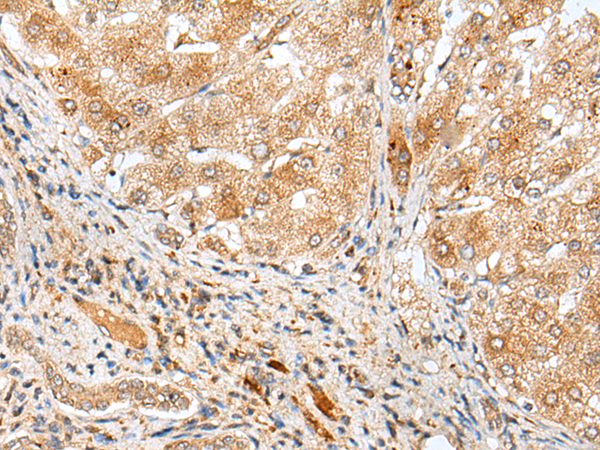

-
分类: 科研抗体货号: P12606别名: NKG2E; NKG2-E应用: IHC反应种属: Human
-
分类: 科研抗体货号: P12585别名: PAR2; GPR11应用: WB反应种属: Human, Mouse, Rat
-
分类: 科研抗体货号: P12597别名: ADAMTS-4应用: IHC反应种属: Human
-
分类: 科研抗体货号: P12604别名: AE3; SLC2C; CAE3/BAE3应用: WB,IHC反应种属: Human, Mouse, Rat
-
分类: 科研抗体货号: P12584别名: ALXDRD应用: WB,IHC反应种属: Human, Mouse, Rat
-
分类: 科研抗体货号: P12595别名: HS1-2; LABH2; PHPS1-2应用: IHC反应种属: Human, Mouse
-
分类: 科研抗体货号: P12603别名: HRX2; MLL2; MLL4; TRX2; WBP7; MLL1B; WBP-7; CXXC10应用: IHC反应种属: Human, Mouse
-
分类: 科研抗体货号: P12582别名: LAH3; P2Y5; ARWH1; HYPT8; P2RY5应用: IHC反应种属: Human, Mouse, Rat
-
分类: 科研抗体货号: P12594别名: M-ABC2; MTABC2; EST20237应用: IHC反应种属: Human
-
分类: 科研抗体货号: P12601别名: G2AN; GIIA; PKD3; GLUII应用: WB,IHC反应种属: Human, Mouse

鄂公网安备42018502007531号
鄂公网安备42018502007531号

